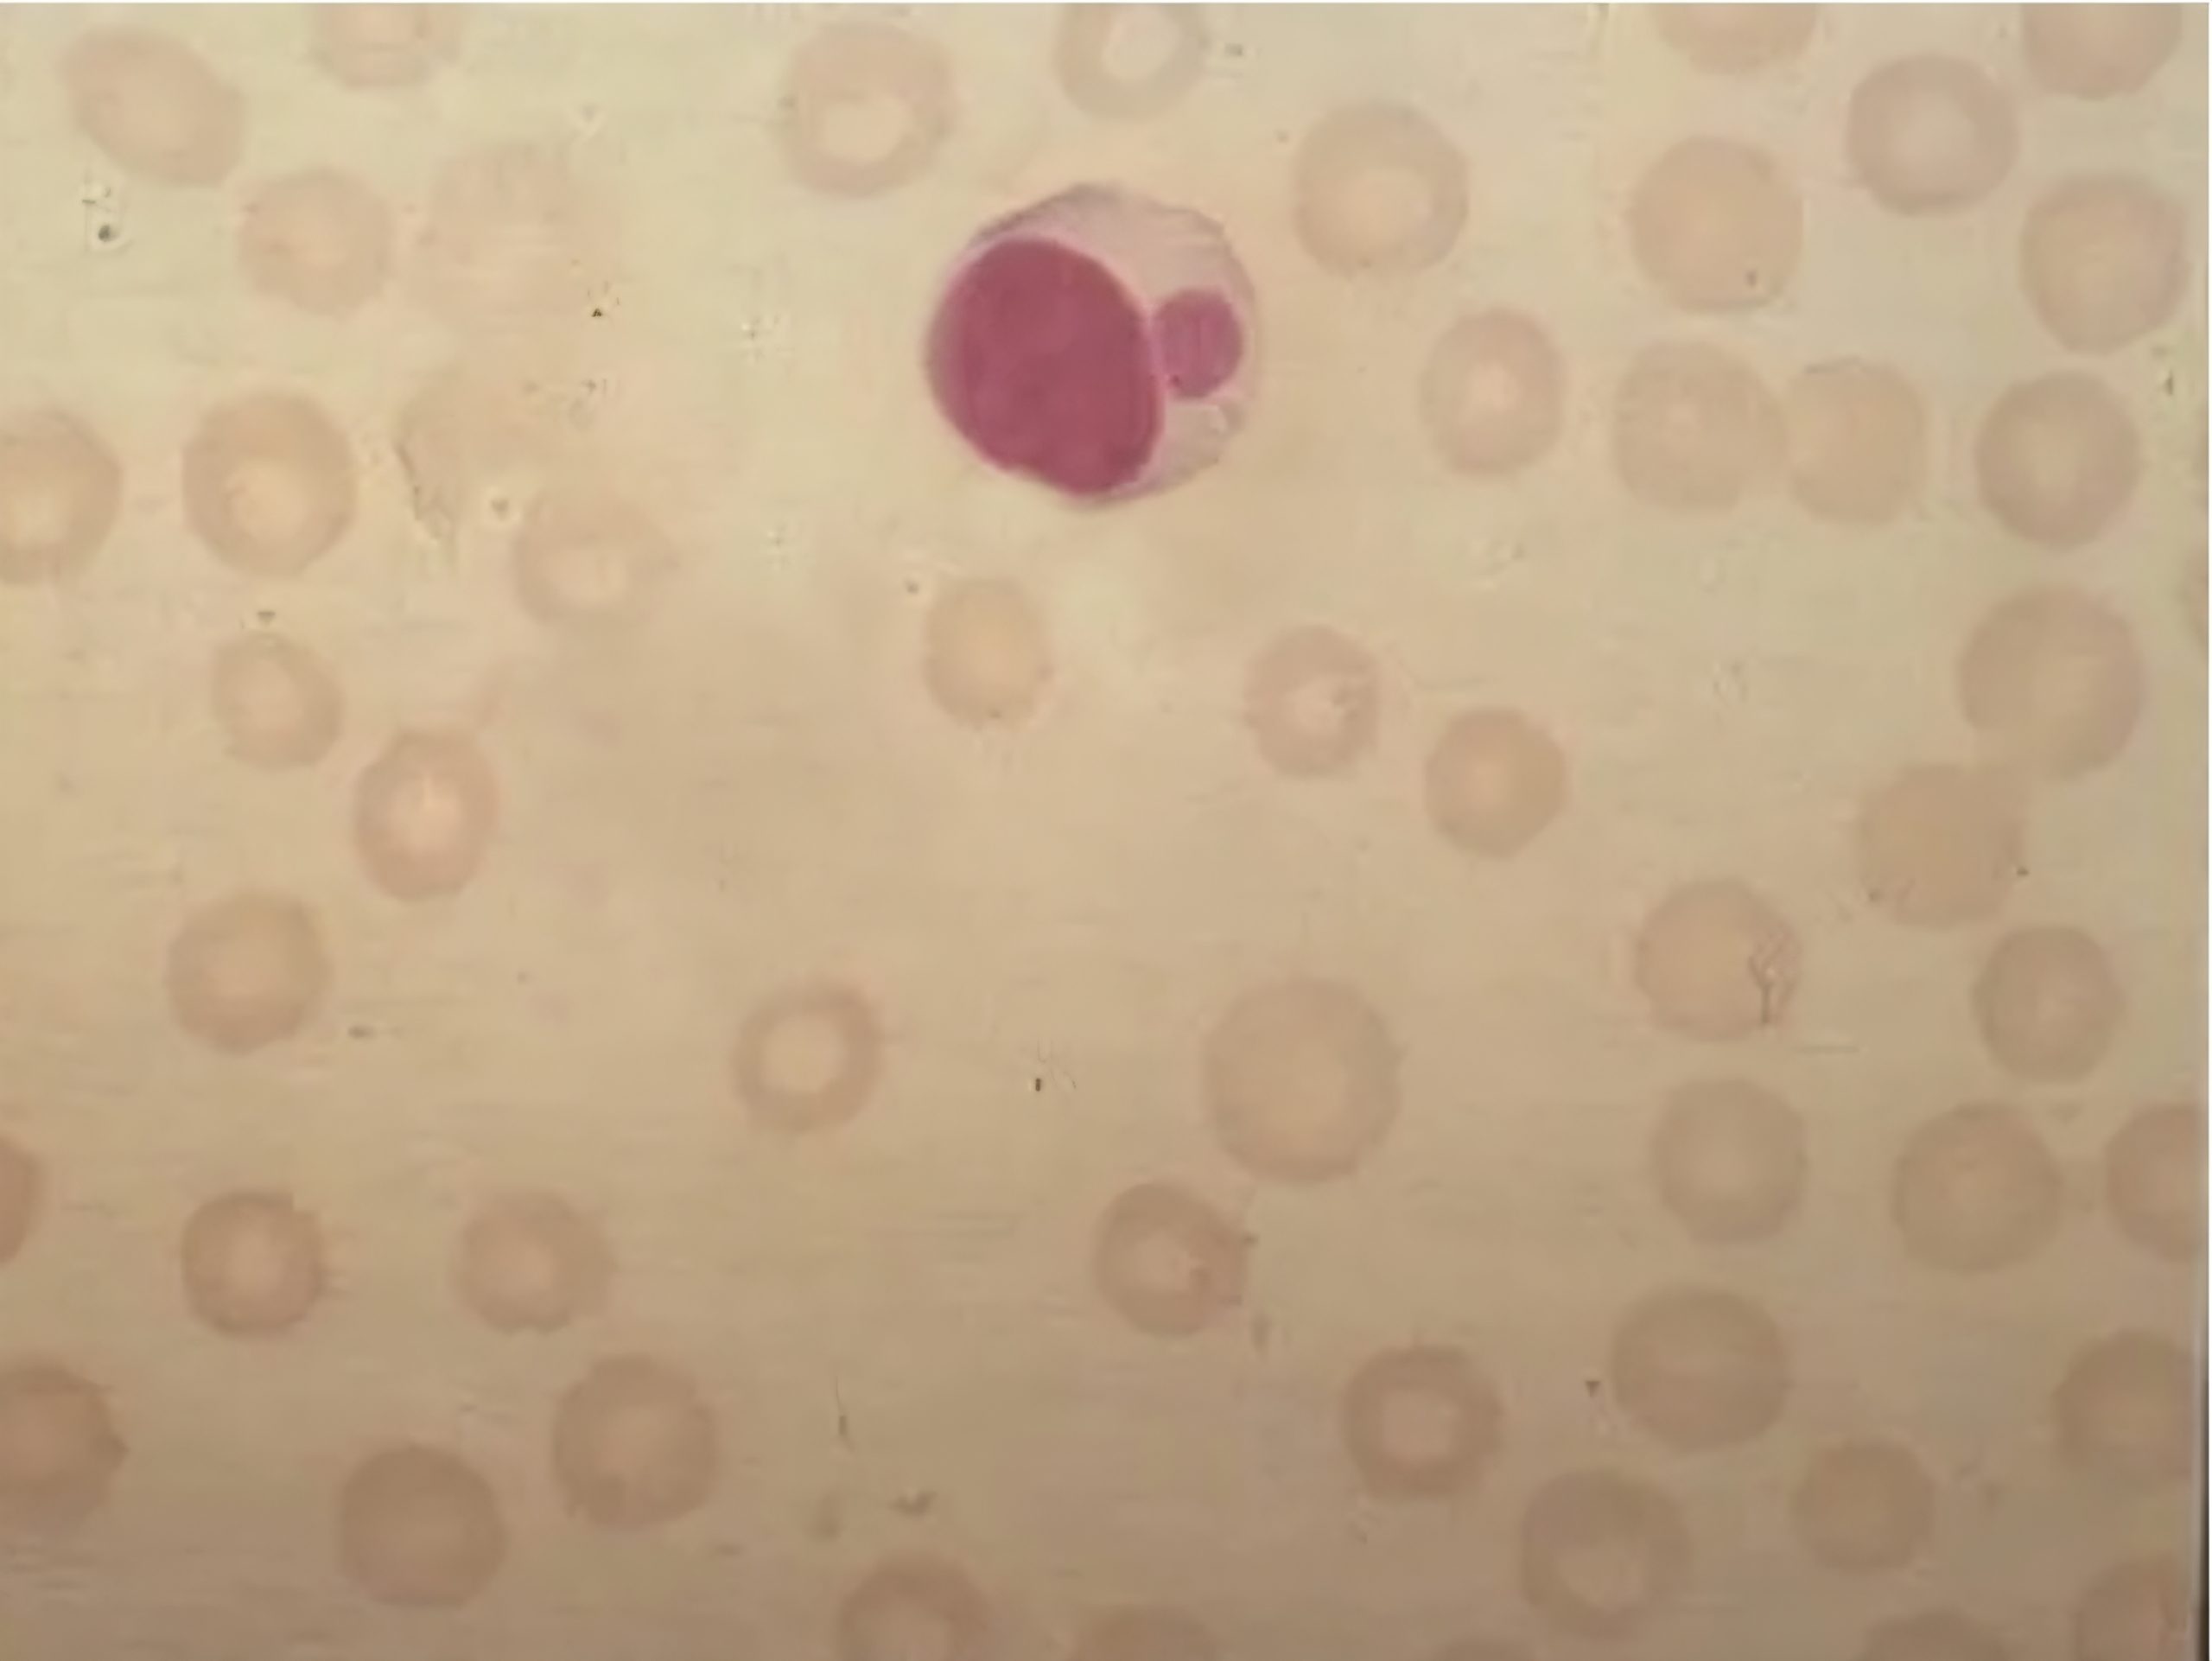

Neue Erkenntnisse zu Übertragungswegen von Ehrlichia canis
„Sie ist topfit, bestens im Futter, der Deckrüde war erprobt – und trotzdem bleibt die Hündin schon wieder leer.“
Viele Züchter kennen solche Situationen. Oft wird dann über Hormone, Fütterung oder den richtigen Deckzeitpunkt spekuliert. Doch eine aktuelle Studie aus Brasilien weist auf einen ganz anderen, bislang kaum beachteten Grund hin: Ehrlichia canis, ein durch Zecken übertragener Erreger, kann nicht nur die Fruchtbarkeit beeinträchtigen, sondern sogar direkt von der Mutterhündin auf die Welpen übergehen.
Überraschender Übertragungsweg
Lange Zeit ging man davon aus, dass sich Hunde ausschließlich über Zecken mit Ehrlichia canis infizieren. Die neue Untersuchung zeigt nun: Das Bakterium kann auch transplazentar – also während der Trächtigkeit – auf die Nachkommen übertragen werden.
Untersucht wurden über fünfzig trächtige Hündinnen aus einem Zeckengebiet. Fast ein Drittel war infiziert. Besonders alarmierend: Ehrlichia-DNA fand sich nicht nur im Blut der Mütter, sondern auch in Plazentagewebe, Organen totgeborener Welpen und sogar in lebend geborenen Jungtieren. Damit ist wissenschaftlich gesichert: Welpen können bereits im Mutterleib infiziert werden.
Warum ist das für Züchter wichtig?
Eine unerkannt infizierte Hündin kann für ihre Nachkommen ein Risiko darstellen – selbst wenn die Welpen nie Kontakt mit Zecken hatten.
Die möglichen Folgen:
> Totgeburten oder resorbierte Früchte
> schwache oder kranke Welpen
> wiederholtes „Leerbleiben“ trotz optimaler Bedingungen
Gerade letzteres ist für die Zuchtpraxis entscheidend: Bleibt eine Hündin mehrfach leer, sollte auch eine Ehrlichia-Infektion in Betracht gezogen werden.
Wenn die Hündin infiziert ist – was tun?
Tierärztliche Abklärung: Nur ein Bluttest (PCR oder Antikörpernachweis) bringt Sicherheit.
Therapie: Häufig wird Doxycyclin über mehrere Wochen eingesetzt. Die Behandlung ist langwierig, aber erfolgreich, wenn rechtzeitig begonnen.
Zuchtpause: Infizierte Hündinnen sollten solange nicht belegt werden, bis eine erfolgreiche Therapie nachgewiesen ist.
Nachkontrolle: Vor einem erneuten Deckakt empfiehlt sich eine erneute Untersuchung.
Praxis-Tipps für Züchter
Blutuntersuchungen von Zuchthündinnen vor dem Decken einplanen
Konsequenter Zeckenschutz rund ums Jahr
Differentialdiagnose: Bei wiederholtem Leerbleiben oder Welpenverlust Ehrlichia canis mit abklären lassen
Fazit
Die Forschung zeigt: Ehrlichia canis ist nicht nur ein Zeckenproblem, sondern kann bereits im Mutterleib Schaden anrichten. Für Züchter bedeutet das: Vorsorge, Tests und konsequente Gesundheitskontrolle sind unverzichtbar.
Cavalcanti C, Bezerra W, Holanda L, et al. (2025). First molecular evidence of vertical transmission of Ehrlichia canis in naturally infected female dogs in Brazil. Veterinary Microbiology.